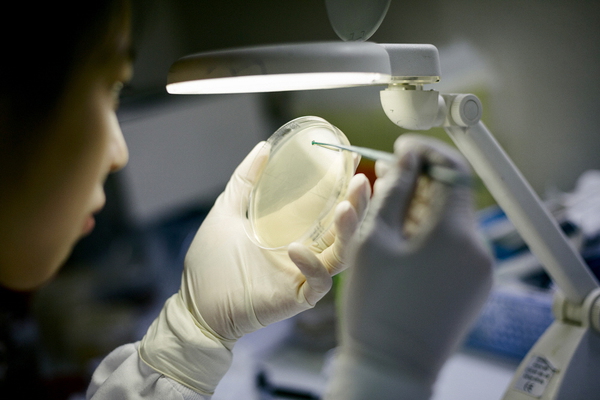

屠呦呦:我最关心青蒿素耐药性问题
新华网北京12月7日电 2015年诺贝尔奖颁奖典礼及晚宴将于12月10日在瑞典首都斯德哥尔摩举行。首位因在中国本土的研究成果获得诺贝尔科学奖的中国科学家屠呦呦,已于4日抵达斯德哥尔摩,参加“诺贝尔周”系列活动。
在6日举行的一场诺奖获得者新闻发布会上,屠呦呦对各国媒体说,她最关心的是疟疾可能对青蒿素产生耐药性这个问题,呼吁有关各方应更加关注并一道努力抗击疟疾。
屠呦呦当天同另外两名生理学或医学奖得主爱尔兰科学家威廉·坎贝尔(下图中)和日本科学家大村智(下图左)共同出席了在瑞典卡罗琳医学院诺贝尔大厅举办的新闻发布会。屠呦呦佩戴亮黄色丝巾,活动主办方还特意为这位80多岁的中国诺奖得主提前准备了一壶贴心的热茶。
谈起自己多年来专注的研究课题,屠呦呦便滔滔不绝地讲述起青蒿素是如何与现代医学相结合并救治病人的。她强调说,自己很担心疟疾在下一个十年有可能泛滥成灾,特别是在非洲地区。“所以,我一直在呼吁,在世界卫生组织的框架下,所有关注疟疾的各方应共同努力。未来十年要再研制出新药是很不容易的事,这个问题应该引起广泛重视,我们要尽可能地延迟疟疾对青蒿素产生耐药性。”
屠呦呦对于青蒿素耐药性问题十分关注。一位西方媒体记者问屠呦呦:得到诺贝尔奖会给她的科研工作带来什么改变?屠呦呦直率地回答说:“当初接受任务的时候,疟疾的危害相当严重。那个时候,我没有过多考虑其他的问题,只是一心想把任务完成。现在,我感觉自己的工作还没有做完,(青蒿素)耐药性问题已经出现,我关心的是这个问题。得奖之后会怎么样?我从来没有考虑过,也不太感兴趣。”